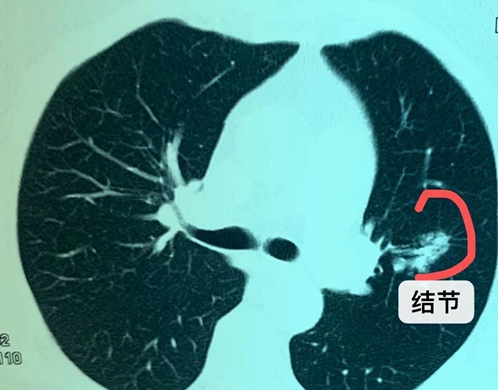
考虑肺癌伴淋巴结转移是肺癌吗,65岁肺癌晚期转移淋巴能活多久

“我经常做运动,生活也很规律啊,不可能患癌吧?”这是一位65岁的阿姨,刚刚退休不久,因为性格开朗,组织能力也强,所以被推选为当地的老干部,平时经常组织社区的老人开展各种活动,在家里,儿孙满堂,生活过得丰富多彩,其乐融融。

阿姨的身体一直很好,就是最近有些咳嗽,所以就去医院看医生。相识的医生朋友建议她还是做一个胸部CT比较好,一是看得比较仔细,二是因为也60多岁了,也该做个检查了解一下肺部的情况。

没想到一做检查,就发现左肺有一个结节。我帮她仔细分析片子后觉得这个结节,从形态上看,不能排除肿瘤。因为内部有一根气管通过。这样的结节大多是肿瘤性生长的,所以建议她做手术。
阿姨百思不得其解,认为自己平时很健康,没有不良的生活习惯,怎么可能会得癌症呢?简单来说,患癌由内因和外因决定,如果有不好的内因基础,就容易诱发癌症。所以,我们在日常生活中,应尽量保持健康的生活方式,尽可能减少患癌的机会。

近日在单孔胸腔镜下给阿姨做了上肺叶切除手术。术中病理证实为肺癌,幸运的是淋巴结都没有转移。还是一个早期的肺癌,治疗效果非常好。